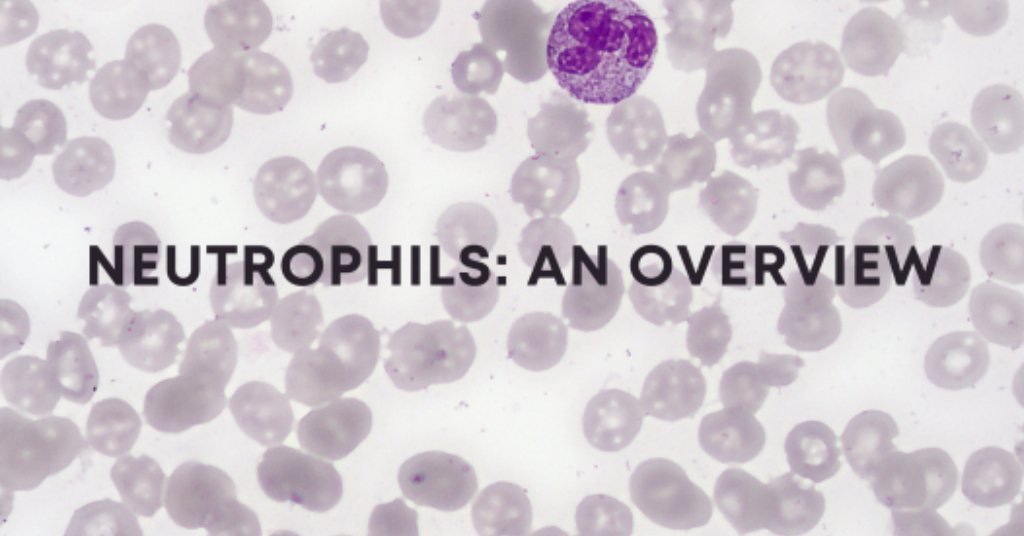

The development and production of biotherapeutics, including monoclonal antibodies, recombinant proteins, and gene therapy vectors, require rigorous control of process- and product-related impurities. These impurities can influence the safety, efficacy, and stability of the final therapeutic product. As regulatory agencies increasingly emphasize the importance of critical quality attributes (CQAs), enzyme-linked immunosorbent assays (ELISAs) have emerged […]